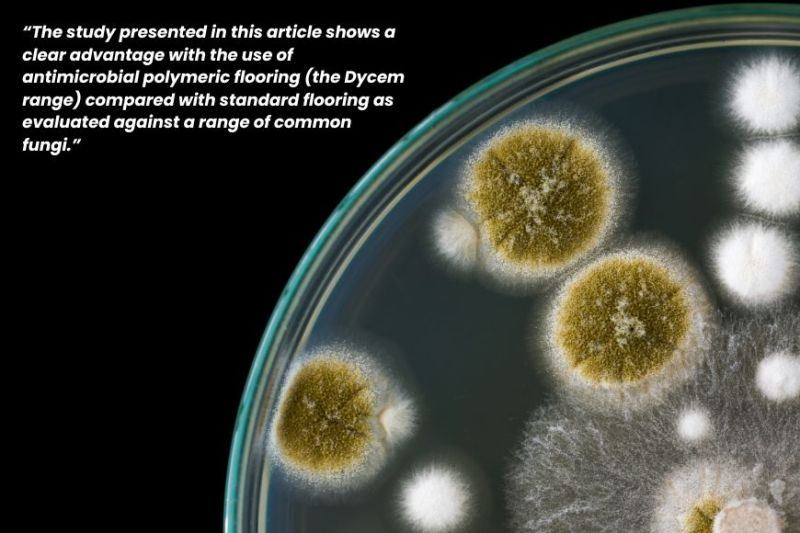
DycemCC's tweet image. Check out this article by Tim Sandle, Ph.D., CBiol, FIScT 👉 Reducing the Fungal Footwear Risk: Evaluating Polymeric Antimicrobial Flooring for Cleanroom Entry.

➡️ eu1.hubs.ly/H0pff_N0

#ContaminationControl #CleanroomTechnology #Fungi #ReduceRisk #Dycem

#contaminationcontrol kết quả tìm kiếm
🚨 Cleanroom contamination is a serious risk! 🚨 Read the full blog here: bit.ly/4ovy5H0 #contaminationcontrol #reducerisk #cleanrooms #cleanroomtechnology
🔄 3 + years lifespan = Less plastic waste in landfills ♻️ Washable & reusable = No more daily disposables 🌱 Sustainably manufactured = Certified to global environmental standards 👉 Book a site survey now: bit.ly/3LlbfTV #ContaminationControl #dycem
Whether foot traffic or wheeled traffic, Dycem is the perfect solution to attract, capture, and retain floor-level contamination. 👇 Stop contamination where it starts! Learn more: bit.ly/3JkmwDu #contaminationcontrol #reducerisk #cleanroomtechnology #pharmaindustry

We’re excited to share that Dycem is a proud sponsor of the 2025 ISPE Annual Meeting & Expo, taking place October 26-29 in Charlotte, NC (and virtually)! 🌟 #ISPE2025 #PharmaManufacturing #ContaminationControl #CleanroomTech



🚨GUARDTECH CASE STUDY ALERT!🚨 An epic Isopod Flow downflow booth straight from our Guardware Cleanroom Hardware equipment range 🤩🤩🤩🤩 Order yours @ iso-pod.co.uk guardtechgroup.com/wp-content/upl… #guardtechroup ⬡⬢⬡⬢⬡⬢ #contaminationcontrol

When you’re in a cleanroom, consistent daily maintenance is critical to controlling particulates smaller than a blood cell. 📽️ Watch the demo: bit.ly/46APQ1u #ContaminationControl #CleanroomMaintenance #GMPCompliance #FacilityManagement #Dycem #Vikan
Medical Technology Ireland is almost here! Find us on the ground floor at Stand 31. Make sure you swing by to pick up a free sample and a pair of our signature funky socks🧦 #contaminationcontrol #reducerisk #medicaltechnology #medicaldevice

Honeywell launches 13MM Pressure Sensor for semiconductor fabs, ensuring high purity, precision, and improved manufacturing yield. #13MMpressuresensor #cleanroomtechnology #contaminationcontrol

Thrilled to partner with PDA: we donated and installed Dycem mats in their training facility so every trainee experiences floor-level contamination control the moment they walk in. #ContaminationControl #PharmaTraining #Dycem
Proud partner moment: we donated and installed Dycem mats at PDA’s training facility. From the first step inside, trainees see how floor-level control works in practice. Watch the install. #Dycem #ContaminationControl #Cleanroom #PharmaTraining #GMP
Join us next week to find out how with guest speaker David Grote, this session offers practical strategies you can apply right away in your facility. 👉 Reserve your seat: bit.ly/4qhR2ym #contaminationcontrol #reducerisk #cleanroom #microbialcontamination

Luckily, Dycem’s here to keep your cleanroom from turning into a horror show - shake off the scares and dance like these skeletons on a spotless Dycem floor. 🦴✨ Keep it clean, creepy, and contaminant-free this Halloween! #Dycem #ContaminationControl #HappyHalloween 💀🕸️🎃

🚨GUARDTECH CASE STUDY ALERT!🚨 Taking dry room provision to new heights with our partnership with Dry Air Ltd! 🪫🔋🪫🔋🪫🔋 guardtechgroup.com/wp-content/upl… #guardtechroup ⬡⬢⬡⬢⬡⬢ #contaminationcontrol #guardtechnordicab #modularcleanrooms #cleanroompods #portablecleanrooms

Lab Innovations... We're back! Come and catch us at the NEC next week for one of the biggest cleanroom and lab shows of the year 👋👋👋👋👋👋 #guardtechroup ⬡⬢⬡⬢⬡⬢ #contaminationcontrol #guardtechnordicab #modularcleanrooms #cleanroompods #portablecleanrooms

If you are attending ISPE Annual Meeting & Expo in Orlando today make sure you stop by the Berkshire Booth #702. See something interesting? Visit our website for more information on our products: hubs.la/Q02Thx1l0 #contaminationcontrol



PDA DelVal Vendor Night Extravaganza tonight at the Desmond Hotel. See you there! 📍 Find us in the Expo Hall — grab some food, network with peers, and don’t forget to enter our raffle for a Sonos speaker! #PDA #VendorNight #ContaminationControl #Dycemc

Meanwhile in the South West... 225sqm of ISO7 Medical Device modular magic continues to take shape Looking fresh, #modsquad 😃😁🥰 #guardtechroup ⬡⬢⬡⬢⬡⬢ #contaminationcontrol #guardtechnordicab #modularcleanrooms #cleanroompods #portablecleanrooms



Looking to improve your #contaminationcontrol strategy? Then you can't afford to miss our most interactive workshop ever! Join us in Raleigh, NC or New Orleans, LA to jumpstart your #CCS understanding and how to apply it to your manufacturing facility. bit.ly/3XOzSdl
Need some new shelving for your cleanroom? 🧐🤔🧐🧐 Head to guard-ware.com/product-catego… to find the ideal solution for your facility. #guardtechroup ⬡⬢⬡⬢⬡⬢ #contaminationcontrol #guardtechnordicab #modularcleanrooms #cleanroompods #portablecleanrooms

Check out this article by Tim Sandle, Ph.D., CBiol, FIScT 👉 Reducing the Fungal Footwear Risk: Evaluating Polymeric Antimicrobial Flooring for Cleanroom Entry. ➡️ eu1.hubs.ly/H0pff_N0 #ContaminationControl #CleanroomTechnology #Fungi #ReduceRisk #Dycem
New release: HVAC Design for Cleanrooms — a complete guide to contamination control, airflow design, and high-tech HVAC systems. Check it out. 🔗 a.co/d/gz786WK I also offer HVAC & cleanroom consulting worldwide. #Cleanrooms #HVAC #ContaminationControl #MEP
Create clear visual cues for your team with customizable warning graphics 👇 Interested in adding warning graphics or Dycem mats to your facility? 📩 Contact us at [email protected] to learn more. #VisualManagement #ContaminationControl #ReduceRisk #CleanroomSafety

For us, it’s all about providing dependable solutions that protect your processes and keep contaminants out, no matter how small. Discover how Dycem can enhance your facility 👉 bit.ly/47zUnBu #contaminationcontrol #electronicsmanufacturing
Effective contamination control is built in layers—no single product can do it all. 📖 Read more from Dr. Tim Sandle: bit.ly/4nXd6Nd #ContaminationControl #CleanroomSafety #StrongerTogether #Dycem #TimSandleNetwork #TimSandle

The Guardtech Group are truly honoured to have played a part in providing a Cleancube Multi 11 container facility for critical, life-saving work in Djibouti 💚💚💚💚 #guardtechroup ⬡⬢⬡⬢⬡⬢ #contaminationcontrol #modularcleanrooms #cleanroompods #portablecleanrooms

Ready to elevate your facility's cleanliness and safety? See how Dycem Contamination Control products work to keep critical environments protected. Let us help meet your facility's unique needs today 👉 bit.ly/4hgWa1A. #ContaminationControl #Dycem #Cleanrooms #Safety
Regulatory science is shaping the future of contamination control. Learn how evidence-based policies are helping life-science manufacturers balance safety, innovation, and compliance. Read more: emmainternational.com #RegulatoryScience #ContaminationControl #LifeSciences

🔄 3 + years lifespan = Less plastic waste in landfills ♻️ Washable & reusable = No more daily disposables 🌱 Sustainably manufactured = Certified to global environmental standards 👉 Book a site survey now: bit.ly/3LlbfTV #ContaminationControl #dycem
AUM Industries designs advanced cleanroom solutions that ensure contamination-free environments for hospitals, pharma labs, and industries where quality and safety come first. #AUMIndustries #CleanRoomSolutions #ContaminationControl #ModularCleanRoom #PharmaInfrastructure




🚨GUARDTECH CASE STUDY ALERT!🚨 An epic Isopod Flow downflow booth straight from our Guardware Cleanroom Hardware equipment range 🤩🤩🤩🤩 Order yours @ iso-pod.co.uk guardtechgroup.com/wp-content/upl… #guardtechroup ⬡⬢⬡⬢⬡⬢ #contaminationcontrol

The ISO range – a new era for cleanroom furniture & equipment at guard-ware.com guardtechcleanrooms.com/news/guardtech… #guardtechroup ⬡⬢⬡⬢⬡⬢ #contaminationcontrol #guardtechnordicab #modularcleanrooms #cleanroompods #portablecleanrooms #cleanroomfurniture #cleanroomequipment
Luckily, Dycem’s here to keep your cleanroom from turning into a horror show - shake off the scares and dance like these skeletons on a spotless Dycem floor. 🦴✨ Keep it clean, creepy, and contaminant-free this Halloween! #Dycem #ContaminationControl #HappyHalloween 💀🕸️🎃

🚨 Cleanroom contamination is a serious risk! 🚨 Read the full blog here: bit.ly/4ovy5H0 #contaminationcontrol #reducerisk #cleanrooms #cleanroomtechnology
Join us next week to find out how with guest speaker David Grote, this session offers practical strategies you can apply right away in your facility. 👉 Reserve your seat: bit.ly/4qhR2ym #contaminationcontrol #reducerisk #cleanroom #microbialcontamination

Whether foot traffic or wheeled traffic, Dycem is the perfect solution to attract, capture, and retain floor-level contamination. 👇 Stop contamination where it starts! Learn more: bit.ly/3JkmwDu #contaminationcontrol #reducerisk #cleanroomtechnology #pharmaindustry

We’re excited to share that Dycem is a proud sponsor of the 2025 ISPE Annual Meeting & Expo, taking place October 26-29 in Charlotte, NC (and virtually)! 🌟 #ISPE2025 #PharmaManufacturing #ContaminationControl #CleanroomTech



Lab Innovations... We're back! Come and catch us at the NEC next week for one of the biggest cleanroom and lab shows of the year 👋👋👋👋👋👋 #guardtechroup ⬡⬢⬡⬢⬡⬢ #contaminationcontrol #guardtechnordicab #modularcleanrooms #cleanroompods #portablecleanrooms

Join us next week to find out how with guest speaker David Grote, this session offers practical strategies you can apply right away in your facility. 👉 Reserve your seat: bit.ly/4qhR2ym #contaminationcontrol #reducerisk #cleanroom #microbialcontamination

Honeywell launches 13MM Pressure Sensor for semiconductor fabs, ensuring high purity, precision, and improved manufacturing yield. #13MMpressuresensor #cleanroomtechnology #contaminationcontrol

🚨GUARDTECH CASE STUDY ALERT!🚨 Taking dry room provision to new heights with our partnership with Dry Air Ltd! 🪫🔋🪫🔋🪫🔋 guardtechgroup.com/wp-content/upl… #guardtechroup ⬡⬢⬡⬢⬡⬢ #contaminationcontrol #guardtechnordicab #modularcleanrooms #cleanroompods #portablecleanrooms

If you are attending ISPE Annual Meeting & Expo in Orlando today make sure you stop by the Berkshire Booth #702. See something interesting? Visit our website for more information on our products: hubs.la/Q02Thx1l0 #contaminationcontrol



Meanwhile in the South West... 225sqm of ISO7 Medical Device modular magic continues to take shape Looking fresh, #modsquad 😃😁🥰 #guardtechroup ⬡⬢⬡⬢⬡⬢ #contaminationcontrol #guardtechnordicab #modularcleanrooms #cleanroompods #portablecleanrooms



225sqm of ISO7 Medical Device magic moves closer! Fab job from Big Miles and the Guardtech Cleanrooms #modsquad #guardtechroup ⬡⬢⬡⬢⬡⬢ #contaminationcontrol #guardtechnordicab #modularcleanrooms #cleanroompods #portablecleanrooms


🚨GUARDTECH CASE STUDY ALERT!🚨 An epic Isopod Flow downflow booth straight from our Guardware Cleanroom Hardware equipment range 🤩🤩🤩🤩 Order yours @ iso-pod.co.uk guardtechgroup.com/wp-content/upl… #guardtechroup ⬡⬢⬡⬢⬡⬢ #contaminationcontrol

Effective disinfection is vital to cleanroom contamination control. Our Alpha, Beta & Delta mopping rotation with sporicidal use ensures Annex 1 compliance, efficacy & cost-effectiveness. Learn more: micronclean.com/news-and-blog/… #Annex1 #GMPCompliance #ContaminationControl

PDA DelVal Vendor Night Extravaganza tonight at the Desmond Hotel. See you there! 📍 Find us in the Expo Hall — grab some food, network with peers, and don’t forget to enter our raffle for a Sonos speaker! #PDA #VendorNight #ContaminationControl #Dycemc

Luckily, Dycem’s here to keep your cleanroom from turning into a horror show - shake off the scares and dance like these skeletons on a spotless Dycem floor. 🦴✨ Keep it clean, creepy, and contaminant-free this Halloween! #Dycem #ContaminationControl #HappyHalloween 💀🕸️🎃

Need some new shelving for your cleanroom? 🧐🤔🧐🧐 Head to guard-ware.com/product-catego… to find the ideal solution for your facility. #guardtechroup ⬡⬢⬡⬢⬡⬢ #contaminationcontrol #guardtechnordicab #modularcleanrooms #cleanroompods #portablecleanrooms

If you missed us at Day 2 of Cleanzone visit hubs.la/Q02Rct3N0 for all of your contamination control product needs. #Cleanroom #ContaminationControl #Cleanzone #CLZ24

Essential, uncompromising performance in a small footprint. At #MirionConnect? Join us for a live demo of the new Mirion Sirius-5 Compact hand-foot contamination monitor. #ContaminationControl #CompactMonitor

Medical Technology Ireland is almost here! Find us on the ground floor at Stand 31. Make sure you swing by to pick up a free sample and a pair of our signature funky socks🧦 #contaminationcontrol #reducerisk #medicaltechnology #medicaldevice

Regulatory science is shaping the future of contamination control. Learn how evidence-based policies are helping life-science manufacturers balance safety, innovation, and compliance. Read more: emmainternational.com #RegulatoryScience #ContaminationControl #LifeSciences

FDA has announced that it is launching “a stronger, more systematic review process” for food chemicals already on the market—especially those that concern consumers most. Learn more: brnw.ch/21wSHKl #ContaminationControl #Chemical

Both Campylobacter and Salmonella cases in England increased by 17.1 percent from 2023 to 2024. UK Health Security Agency (UKHSA) and Food Standards Agency (FSA) experts are investigating the reasons behind the increase. Learn more: brnw.ch/21wTNaW #ContaminationControl

Something went wrong.
Something went wrong.
United States Trends
- 1. #AcousticPianoSnowGlobe 1,398 posts
- 2. #TSTheErasTour 1,243 posts
- 3. #NXXT_NEWS N/A
- 4. Nano Banana Pro 8,767 posts
- 5. Dick Cheney 11.2K posts
- 6. YOYOK N/A
- 7. FINAL DRAFT FINAL LOVE 185K posts
- 8. #LoveDesignFinalEP 167K posts
- 9. #WeekndTourLeaks N/A
- 10. Good Thursday 38.4K posts
- 11. Haymitch 11.8K posts
- 12. Nnamdi Kanu 131K posts
- 13. Pablo 67K posts
- 14. Reaping 75.8K posts
- 15. The Hunger Games 86.1K posts
- 16. sohee 37.1K posts
- 17. Happy Friday Eve 1,028 posts
- 18. Happy Birthday Erika 3,367 posts
- 19. Unemployment 30.1K posts
- 20. Husqvarna N/A














